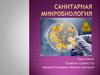
Санитарная микробиология

Similar presentations:
Санитарная микробиология
1. Презентация на тему: Санитарная микробиология
Выполнили: студенты741 группы 2 бригады
2. Санитарно-микробиологическое исследование воды
Отбор проб воды:Пробы воды отбирают в стерильные
бутылки или специальными приборами
батометрами
Пробу берут в количестве 400-500 мл
Доставить воду необходимо в течении 2
часов.
Исследование включает определение :
общее количество бактерий в 1 мл воды;
количество микроорганизмов , колииндекс, коли-титр;
определяют наличие патогенных микробов
в воде.
Батометр
3. Техника сбора, хранения и транспортировки проб воды
При исследовании воды из распределительных сетей отбор проб изкрана производят после предварительной его стерилизации
обжиганием и последующего спуска воды не менее 10 минут при
полностью открытом кране. После наполнения емкость закрывают
стерильной пробкой и колпачком. Отобранную пробу маркируют и
сопровождают актом отбора проб воды с указанием названием пробы,
места забора, даты (год, месяц, число, час), цель исследования, куда
направляется проба для исследования, подпись лица, взявшего пробу.
Доставка проб осуществляется в контейнерах-холодильниках при
температуре 4-10°С. В холодный период года контейнеры должны быть
снабжены термоизолирующими материалами, обеспечивающими
предохранение проб от промерзания. При соблюдении указанных
условий срок начала исследований от момента отбора проб не должен
превышать 6 часов. Если пробы нельзя охладить, их анализ следует
провести в течение 2 часов после забора.
4. Бродильный метод
заключается в посеве определенных объемов воды и выращивании при 430 5 С в жидкой питательной среде накопления ( с поплавками) с последующим высевом
бактерий на плотную агаровую среду Эндо, дифференцировании вероятного числа кишечных
палочек в 1 л воды.
Для исследования минеральной воды бродильным методом используют 2 объема по 100 мл и
10 объемов по 10 мл. Указанные объемы воды засевают в концентрированную
глюкозопептонную среду Эйкмана, Посевы выращивают при 43 С в течение 18 - 24 часов.
Затем производят пересев на чашку со средой Эндо и выросшие колонии при 37 С после
микроскопии идентифицируют по вторичной бродильной пробе.
5. Метод мембранных фильтров
Метод определения количества клеток E.coli в единице объема жидкости(коли-индекс); суть метода заключается в фильтровании анализируемой
жидкости через мембранные фильтры, задерживающие бактерии, после
чего фильтры помещают на среду Эндо, ставят в термостат вверх дном и
инкубируют посевы при температуре (37 + 1)°С в течение 24 + 2 часов.
6. Санитарно-микробиологическое исследование почвы
Отбор проб почвы:Пробы почвы отбираются на каждом из участков в его пяти точках по диагонали
или по «конверту» (четыре точки по углам и одна в центре) по 500г.
Подготовка и обработка почвы для анализа :
Для приготовления среднего образца объемом 0,5 кг почву всех образцов
одного участка высыпают на стерильный плотный лист бумаги, тщательно
перемешиваю, отбрасывают камни и прочие твердые предметы. Затем
распределяют на месте ровным тонким слоем в форме квадрата. Диагоналями
почву делят на 4 треугольника. Почву из двух противоположных треугольников
отбрасывают, а оставшуюся вновь перемешивают, опять распределяют тонким
слоем и делят диагоналями и так до тех пор, пока не останется примерно 0,5 кг.
Перед посевом почву просеивают через сито диаметром 3 мм.
7. Определяемые показатели при исследование почвы
К методам определения микробиологических показателей, характеризующих фекальное загрязнение почвы, относятсяследующие:
1. Определение количества бактерий группы кишечных палочек, энтерококков, энтеровирусов.
2. Определение кишечных палочек в почве титрационным методом.
3. Определение кишечных палочек в почве методом мембранных фильтров.
4. Прямой поверхностный посев на агаризованные питательные среды для учета кишечных палочек в почве.
5. Определение в почве общего количества бактерий,
6. Определение Clostridium perfringens в почве.
К методам определения микроорганизмов, характеризующих загрязнение и самоочищение почвы от органических и
химических загрязнений, относятся:
1. Определение общей численности почвенных сапрофитных микроорганизмов.
2. Определение общей численности почвенных микроорганизмов методом прямой микроскопии.
3. Определение общего числа и процента почвенных бацилл.
4. Определение количества грибов и актиномицетов в почве.
5. Определение аэробных целлюлозоразлагающих микроорганизмов.
6. Определение аммонификаторов в почве.
7. Определение токсичности почв к микроорганизмам.
К методам определения патогенных бактерий и вирусов в почве относятся следующие:
1. Определение сальмонелл в почве.
2. Индикация и выделение патогенных клостридий из почвы.
3. Идентификация и выделение столбнячной палочки.
4. Индикация и выделение ботулинической палочки.
5. Обнаружение сибиреязвенной палочки в почве.
8. Определение Clostridium perfringens в почве
Из всех приготовленныхпочвенных разведений (до 1 :
1000 000) по 1 мл переносится в
два параллельных ряда
пробирок. Один ряд пробирок
прогревают при температуре
80°С в течение 15 минут или
при 90°С — 10 минут. Затем во
все пробирки наливают по 9—
10 мл среды Вильсон— Блер.
Инкубация посевов
производится при 37° С в
течение 24 часов.
Cl. perfringens образуют
колонии черного цвета, в мазках
— грамположительные палочки.
9. Санитарно-микробиологическое исследование воздуха
Исследования проводят как в плановом порядке, так и по эпидемиологическимпоказаниям. Бактериологическое исследование воздушной среды
предусматривает:
— определение общего содержания микробов в 1 м3 воздуха;
— определение содержания золотистого стафилококка в 1 м3 воздуха.
Отбор проб воздуха для бактериального исследования проводят в следующих
помещениях:
* операционных блоках;
* перевязочных;
* послеоперационных палатах;
* родильных залах;
* палатах для новорожденных;
* палатах для недоношенных детей;
* послеродовых палатах;
* отделениях и палатах интенсивной терапии и других помещениях, требующих
асептических условий.
10. Методы забора проб
Существуют два основных способа отбора пробвоздуха для исследования:
1. седиментационный — основан на
механическом оседании микроорганизмов;
2. аспирационный — основан на
активном просасывании воздуха
(этот метод дает возможность
определить не только качественное,
но и количественное содержание
бактерий). ( ЕА 100 АЦ ) =>
11. Санитарно-микробиологическое исследование пищевых продуктов
Пищевые продукты, содержащие большое количество питательныхвеществ, являются благоприятной средой для существования и
размножения микробов. Микрофлора, которая встречается в
пищевых продуктах, может быть специфической и неспецифической.
Специфическая микрофлора состоит из тех микроорганизмов,
которые обусловливают вкусовые и питательные свойства
продуктов, например молочнокислые бактерии в кисломолочных
продуктах и квашеных овощах. Неспецифическая микрофлора
представлена случайно попавшими в пищевые продукты микробами
из внешней среды. Некоторые из них не оказывают влияния на
пищевые продукты, другие делают их непригодными для
употребления и даже вредными, например, картофельная палочка,
вызывающая «тягучую болезнь хлеба», бактерии, являющиеся
причиной ослизнення напитков, и др. Санитарно-показательные и
патогенные микроорганизмы также относят к неспецифической
микрофлоре.
12.
Для микробиологических анализов пробы отбирают по ГОСТ Р 534302009.Определения качества молока и молочных продуктов важно установить нетолько общее количество содержащихся в них микробов, из которых некоторые
обладают полезными качествами. но и выявить бактерии кишечной палочки
(эшерихий), являющиеся санитарно-показательными микроорганизмами.
Среда ПЖ-65 предназначается для выделении из молока, сливок, сметаны, творога,
масла и сыров бактерий кишечной палочки и сальмонелл. Среду готовят по
следующей прописи (в г): лактозы 20,0. фосфорно-кислого калия (двузамещенного) 3,0, питательного агара (в порошке) - 50,0, стерилизованной желчи крупного рогатого
скота - 100 мл, 1% -ного спиртового раствора бриллиантовой зелени-2 мл. Указанные
компоненты растворяют при подогреве и помешивании в 900 мл дистиллированной
воды, устанавливают рН 7,2-7,3, разливают столбиком в пробирки по 5 мл,
прогревают текучим паром при 100° в течение 15 минут, охлаждают до 45-46° и
вносят в пробирки со средой разведения молока или молочного продукта,
предварительно растертого в стерильной ступке с физиологическим раствором
хлорида натрия аС1, Высевы из молока и продуктов делают в разведениях 1: 5, 1: 10,
1: 100, 1: 1000 и т.д. Инкубируют в термостате при температуре 43-44е.
13.
При наличии в продуктеэшерихий, даже в разведениях до
10"9 через 16-18 часов
инкубирования происходит
разрыв столбика среды, но
первоначальный ее зеленый цвет
не изменяется. При росте
сальмонелл среда приобретает
оливковый цвет, без разрыва ее
массы. Грамположительные
микроорганизмы на среде "ПЖ65" не развиваются.
Производственная проверка этой
среды в десяти областных
ветеринарных лабораториях
Украины показала, что она
значительно сокращает срок
анализа при обнаружении в
молоке и молочных продуктах
бактерий кишечной палочки.
14. Санитарно-микробиологическое исследование Мяса
Мясо и мясные продукты подвергают бактериологическому исследованию во всехслучаях, когда предполагается обсеменение их возбудителями инфекций,
патогенными для человека, или же микрофлорой, вызывающей порчу продуктов.
Готовая продукция также исследуется в порядке санитарно-бактериологического
контроля.
Взятие проб. Пробы берут стерильным ножом из разных частей туши. Каждую пробу
мяса или органов в количестве 200 г заворачивают в чистую пергаментную бумагу, на
которой ставят номер. Несколько проб, взятых от одной туши, упаковывают в
бумажный пакет, пломбируют и направляют в лабораторию. В сопроводительном
документе обозначают дату и место взятия проб от животного, номер туши, причину
и цель исследования. Все эти сведения заверяются подписью отправителя.
Колбасные изделия. Колбасные изделия подвергаются бактериологическому
исследованию в случаях обнаружения фактов использования в производстве
подозрительного в отношении доброкачественности мясного сырья, нарушения
санитарно-гигиенического режима производственных процессов, получения
сомнительных данных при органолептической оценке продукта. Отобранные образцы
завертывают в пергаментную или оберточную бумагу (каждый из них нумеруется в
отдельности), упаковывают в один пакет, опломбировывают и направляют в
лабораторию, приложив акт об изъятии образцов, в котором указывается место и дата
отбора и изготовления пробы, название продукта, его сорт, причина и цель исследования
15.
Исследование мяса состоит из следующих этапов:1. Органолептическая оценка мяса.
2.Микроскопическое исследование препаратов,
приготовленных из мяса, окрашенных по Граму, на капсулу и
споры.
3.Первичный посев на МПА, МПБ, селективные и
специальные среды, среды обогащения.
4.Идентификация выделенных культур по морфологическим,
культурально-биохимическим и антигенным свойствам.
5.Заражение лабораторных животных в необходимых
случаях.
Продолжительность бактериологического исследования мяса
3 суток, при постановке биопробы до 10 суток. Исследуемые
туши после взятия проб помещают в холодильник-изолятор
при температуре 0-40С.
16.
1. Органолептическая оценка мяса. Доброкачественное мясо при подсыханииобразует корочку бледно-красного цвета. На разрезе оно плотное, эластичное, ямка
после надавливания быстро исчезает. Несвежее мясо покрыто плотной, темно-красной
или ослизненной корочкой. Консистенция его мягкая, несколько дряблая, образующаяся
при надавливании ямка восстанавливается. Поверхность испорченного
мяса ослизненная, консистенция дряблая, мажущаяся; жир слизистый с прогорклым
запахом – такое мясо бракуют.
2.Для микроскопического исследования мяса из каждой пробы готовят препаратыотпечатки для окрашивания по Граму, на наличие капсул - по Ольту или Михину. В
каждом препарате изучают не менее 25 полей зрения.
Для приготовления препарата-отпечатка стерильными ножницами вырезают из
середины каждого образца кусочек размером 1,5х2х2,5 см и прикладывают к
предметному стеклу местом свежего среза. Делают по 3 отпечатка на 2-3 предметных
стеклах. Мазки высушивают на воздухе или в струе теплого воздуха над пламенем
горелки. Мазки можно фиксировать физическим или химическим методом. При
химическом методе фиксации препараты погружают в метанол на 5 мин или на 15 мин в
смесь Никифорова (равные объемы спирта и эфира), окрашивают по Граму и
подсчитывают количество микроорганизмов в каждом поле зрения, учитывая отдельно
шаровидные и палочковидные
17.
Мясо считается свежим, если в мазках-отпечаткахне обнаружена микрофлора или в поле зрения
препарата видны единичные (до 10 клеток) кокки
и палочковидные бактерии и нет следов распада
мышечной ткани. Препарат-отпечаток из мяса
сомнительной свежести окрашивается
удовлетворительно, видны следы распада
мышечной ткани, ядра мышечных волокон в
состоянии распада. При просмотре в каждом поле
зрения обнаруживается не более 30 кокков или
палочек.
Препарат-отпечаток из мяса непригодного в пищу,
окрашивается хорошо. В поле зрения в
препаратах, как из поверхностных, так и из
глубинных слоев преобладают палочки. При
сильном разложении мяса кокки почти
отсутствуют, все поле зрения состоит из палочек.
Среди них могут быть кишечные палочки,
флуоресцирующие бактерии, спорообразующие
бактерии. (Из аэробных спорообразующих
бактерий – Bac.subtilis, Bac.mycoides; из
факультативно-анаэробных – Proteus vulgaris, из
анаэробных - Cl.putrificus, Cl.sporogenes).
18. Санитарно-микробиологическое исследование консервов
Бактериологическое исследование готовых консервов проводится по ГОСТ 30425—97. Консервы.Метод определения промышленной стерильности, ГОСТ 10444.15—94. Продукты пищевые. Методы
определения количества мезофильных аэробных и факультативно-анаэробных микроорганизмов.
Анализ готовой продукции проводится лабораториями центров Госсанэпиднадзора, как правило, с
целью установления промышленной стерильности консервов. Консервированные продукты,
удовлетворяющие требованиям промышленной стерильности, не должны представлять опасность для
здоровья потребителя и не должны портиться во время хранения. Готовые консервы не должны
содержать патогенных микробов и иметь признаков порчи, обусловленных жизнедеятельностью
микробов
.Отбор проб для исследования (ГОСТ 26668—85)
Проводят внешний осмотр банок. Отмечают наличие ржавчины, деформации, подтеков. В журнале
записывают маркировку жестяных банок, со стекляных банок отклеивают этикетку. Тщательно моют
банки теплой водой с мылом, насухо обтирают.
Проверяют герметичность банок. Для этого в эксикатор наливают свежеприготовленную в течение 15
с и охлажденную до 40—45°С воду, опускают на дно эксикатора банки и наблюдают за пузырьками
воздуха. Негерметичной считается банка, у которой из одного и того же места выходит струйка
воздуха или периодически несколько пузырьков.Негерметичные банки бактериологическому
исследованию не подлежат. Герметически упакованные, бездефектные по внешнему виду консервы
подвергаются термостатной выдержке до 10 дней при 30—55°С в зависимости от консервов для
проверки на бомбаж. О наличии бомбажа судят по вздутию дна или крышки банки. Вскрытие банки и
посев консервов производят при строгом соблюдении правил асептики (в боксах).
19. Подготовка к микробиологическому исследованию
Банки тщательно моют теплой водой и вытирают. Затем крышку банкипротирают смоченным в спирте тампоном, фламбируют и вскрывают
консервным ножом. Проводят органолептическое исследование: определяют
внешний вид, цвет, запах и состояние содержимого. Органолептические
признаки специфичны для каждого вида консервов, они должны отвечать
требованиям стандартов и технических условий.
Из каждой консервной банки отбирают одну или несколько навесок,
предназначенных для непосредственного высева и приготовления
последовательных разведений для проведения всех видов исследования. Навеску
для посева отбирают весовым или объемным методом после вскрытия банки
консервов в условиях исключающих микробное загрязнение, в образце
должны быть представлены все компоненты и в том же соотношении, что и в
продукте.
Стерильность консервов определяют в случаях, когда они выработаны по
специальным заказам и для поставок экспедициям, космонавтике и лечебным
учреждениям.
20. Выявление БГКП
Для индикации и определения БГКП предусматривают установление наличия БГКП в определенной навескепродукта и подсчет их количества. По микробиологическим нормативам не допускается наличие БГКП в 1 г
консервированного мяса.
Методика. Для индикации БГКП проводят посев по 1 г натурального продукта и из разведений 1:10, 1:100 в
среду Кесслера. Посевы культивируют 24 ч в термостате при 370С, предварительный учет проводят через 24
ч, окончательный – через 48 ч. При отсутствии признаков роста делают заключение об отсутствии БГКП в
исследуемом продукте
При появлении роста, признаками которого являются помутнение среды, образование газа, изменение цвета
среды, проводят дальнейшие исследования. Для подтверждения принадлежности микроорганизмов к
бактериям группы кишечной палочки, из проросших пробирок делают высев 0,1 мл культуральной
жидкости на одну из дифференциально-диагностических сред – агар Эндо или агар Смирнова (характерно
появление желтых колоний). Посевы инкубируют в термостате при 370С в течение 24 ч. Из изолированных
колоний по своим культуральным признакам характерных для кишечной палочки делают препараты,
окрашивают по Граму, изучают тинкториальные и морфологические признаки.
В некоторых случаях можно проводить первичный посев 0,1 мл исходного продукта или из 10-кратного
разведения непосредственно на поверхность дифференциально-диагностических сред (Эндо), что позволит
дать заключение о наличии (или отсутствии) БГКП в определенной навеске продукта уже через 24 часа. Не
менее чем в 5-ти колониях изучают морфологию микроорганизмов в мазках, окрашенных по Граму.
Обнаружение коротких с закругленными концами грамотрицательных палочек, специфически изменяющих
цвет жидких дифференциально-диагностических сред и образующих характерные колонии на элективных
средах с лактозой, указывает на наличие БГКП. В заключении указывают, обнаружены или отсутствуют
БГКП в 1 г исследуемого продукта.
21. Выявление сальмонелл
Индикация сальмонеллв связи с тем, что они присутствуют в консервах в небольшом количестве,проводится в четыре этапа:
- предварительное обогащение – выдерживание пробы в термостате в жидкой неселективной среде
(буферная, пептонная вода, МПБ) при 370С;
- обогащение – посев предварительно обогащенной среды в две жидкие селективные среды (селенитовый
бульон, тетратионатная среда) с последующим выдерживанием в термостате соответственно при 37 или
420С в течение 24-48 ч, (в этих средах происходит накопление энтеробактерий и подавление
сопутствующей микрофлоры);
- пересев с двух обогащенных сред на плотные селективно-дагностические среды в чашках Петри (БФагар, среда Эндо), которые после выдерживания в термостате при 370С исследуют на наличие колоний,
по своим характеристикам подозрительных на сальмонеллы;
- идентификация – пересев подозрительных на сальмонеллы колоний и определение культуральнобиохимических и антигенных свойств выделенных микроорганизмов.
Методика. Для проведения исследования измельчают навеску продукта массой 25 г с соблюдением правил
асептики. Затем измельченную навеску гомогенизируют в 225 мл буферной пептонной воды (получается
разведение 1:10), помещают в термостат при 370С на 16-20 ч. После этого по 10 мл пептонной воды
пересевают в две колбы со 100 мл среды (в первой колбе тетратионатная среда, во второй – селенитовая).
Колбы помещают в термостат: первую при 420С, а вторую – при 370С. Через сутки бактериологической
петлей проводят пересев на БФ-агар и висмут-сульфитный агар (чаще используют агар Эндо), чтобы
получить изолированные колонии. Из подозрительных колоний готовят мазки, окрашивают по Граму,
определяют подвижность в препарате «висячая» или «раздавленная капля»
22. Санитарно-микробиологическое исследование смывов с рук
При взятии смывов с рук протирают тампоном ладонные поверхности обеихрук, проводя не менее 5 раз по каждой ладони и пальцам, затем протирают
межпальцевые пространства. исследование проводится для определения :
наличия БГКП; общею обсемененность с пересчетом на 1см2 исследованной
площади; в наличии Staphylococcus aureus и др патогенных микробов. Для
определения общего числа микробов в исследуемом смыве к 2 мл
изотонического раствора используемого для увлажнения тампона
прибавляют еще 8 мл и тампон тщательно отмывают встряхиванием,
полученное исходное разведение 1:10 вносят в чашке Петри и инкубируют
при 38*С 48 часов, затем подсчитывают кол-во колоний и делая пересчет на
1см2 Для определения БГКП производят посев в среду Кесслера или в 1020% желчный бульон. Через сутки инкубирования при 37 градусов делают
пересев на среду ЭНДО после инкубации в термостате при 37 градусов в
течении 24 часов подозрительные колонии микроскопируют и пересевают на
среду Гисса с глюкозой и выдерживают при 43 градусов 24 часа, после
производят учёт результатов.






















 biology
biology